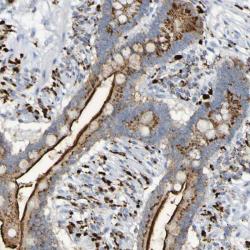

Antibody data
- Antibody Data
- Antigen structure
- References [0]
- Comments [0]
- Validations
- Immunohistochemistry [1]
Submit
Validation data
Reference
Comment
Report error
- Product number
- T0678 - Provider product page

- Provider
- MilliporeSigma / Merck KGaA
- Product name
- Monoclonal Anti-Tryptophan Hydroxylase antibody produced in mouse
- Antibody type
- Monoclonal
- Reactivity
- Human, Rat, Rabbit, Simian
- Host
- Mouse
- Conjugate
- Unconjugated
- Isotype
- IgG
- Antibody clone number
- WH-3
- Storage
- Store at -20°C
No comments: Submit comment
Supportive validation
- Submitted by
- per
- Main image
- Experimental details
- Immunohistochemical staining of human colon shows strong cytoplasmic and membranous positivity in glandular cells.
- Validation comment
- Staining pattern partly consistent with experimental and/or bioinformatic data.
 Explore
Explore Validate
Validate Learn
Learn Western blot
Western blot